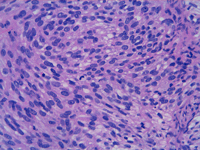

Volumen 20 - Número 2 - Abril-Junio 2012
Sarcoma palpebral radioinducido
M. López López1, B. Dias Medeiros1, F. Mascaró Zamora1, X. Acebes Roldán1, X. Sanjuán i Garriga2
1Servicio de Oftalmología. Hospital Universitari de Bellvitge
2Servicio de Anatomía Patológica. Hospital Universitari de Bellvitge
2Servicio de Anatomía Patológica. Hospital Universitari de Bellvitge
CORRESPONDENCIA
Montse López López
Hospital Universitari de Bellvitge
Servicio de Oftalmología
Feixa Llarga, s/n
08907 L’Hospitalet de Llobregat. Barcelona.
E-mail: montselop6@hotmail.com
Hospital Universitari de Bellvitge
Servicio de Oftalmología
Feixa Llarga, s/n
08907 L’Hospitalet de Llobregat. Barcelona.
E-mail: montselop6@hotmail.com
RESUMEN
Un paciente de 22 años con antecedentes de retinoblastoma bilateral consultó por una tumoración subpalpebral inferior en su ojo derecho de 5 días de evolución. Había recibido tratamiento con radioterapia externa a los 6 meses de vida y a los 9 meses de edad requirió enucleación de su ojo izquierdo. La TC de órbita demostró un proceso expansivo en la región supero-externa del globo ocular derecho, por lo que se practicó una biopsia excisional de la lesión. El diagnóstico diferencial se establece entre el sarcoma sinovial fusocelular, el tumor maligno de vaina nerviosa periférica y sarcoma radioinducido. El material obtenido se etiquetó como sarcoma radioinducido fusiforme grado 3.
RESUM
Un pacient de 22 anys amb antecedents de retinoblastoma bilateral va consultar per una tumoració subpalpebral inferior al seu ull dret de 5 dies d’evolució. Va rebre tractament amb radioteràpia externa als 6 mesos de vida, i a l’edat de 9 mesos va requerir enucleació del seu ull esquerre. La TC d’òrbita va demostrar un procés expansiu a la regió supero-externa del globus ocular dret, motiu pel qual es va practicar una biòpsia excisional de la lesió. El diagnòstic diferencial comprén el sarcoma sinovial fusocel•lular, el tumor maligne de la beina nerviosa perifèrica i el sarcoma radioinduït. El material obtingut es va etiquetar de sarcoma radioinduït fusiforme grau 3.
ABSTRACT
A 22-year-old man complained of a subpalpebral mass in his right lower eyelid that appeared 5 days ago. He had been diagnosed of bilateral retinoblastoma that was treated with external radiotherapy at the age of 6 months, he required enucleation of the left eye at the age of 9 months old. Orbit CT scan detected a mass located in the lower outer region of the orbit which underwent excisional biopsy. Differential diagnosis proposed was spindle cell synovial sarcoma, malignant tumor of peripheral nerve sheath, and radiation-induced sarcoma. Pathologic study revealed grade 3 radioinduced spindle cell sarcoma.
Introducción
Los sarcomas radioinducidos son tumores malignos que aparecen como un efecto indeseable del tratamiento con radiación externa generalmente dentro de la zona irradiada. El tiempo de latencia para la aparición del sarcoma secundario varía entre los 4 y los 45 años Los factores de riesgo son dependientes de la edad del paciente (mucho mayor en menores de un año)1, de la duración del tratamiento y de la dosis total recibida2. En los últimos cien años la radiación externa ha sido uno de los pilares para el tratamiento de pacientes con retinoblastoma intraocular. En la actualidad se utiliza la braquiterapia e incluso la quimioterapia intraarterial.Caso clínico
Un joven de 22 años consultó por la aparición súbita e indolora de una tumoración subpalpebral en su párpado inferior derecho de 5 días de evolución. No presentaba ninguna otra sintomatología acompañante. Se destaca que a los 6 meses de edad el paciente fue diagnosticado de retinoblastoma bilateral, fue tratado con radioterapia externa en ambos ojos, y requirió enucleación del ojo izquierdo a los 9 meses de vida. La madre padeció un retinoblastoma unilateral en la infancia que fue tratado mediante enucleación.La exploración inicial detectó una agudeza visual del ojo derecho 0,4 (hasta 0,6 con estenopeico). Presentaba una tumoración subpalpebral más evidente en la supraducción, no se observaban limitaciones en los movimientos oculares.
La biomicroscopia del segmento anterior fue normal, con presión intraocular (PIO) de 16 mmHg. La exploración del segmento posterior bajo midriasis mostró placas planas coriorretinianas blanquecinas, compatibles con cicatrices del retinoblastoma post-radioterapia.
La TAC orbitaria identificó una tumoración ovalada de 6,8x13, 3x14, 1mm, en región supero-externa del globo ocular derecho de una densidad similar a partes blandas, con aspecto moderadamente heterogéneo sugestivo de proceso expansivo (Figura 1). Dados los antecedentes patológicos del paciente y el crecimiento agudo de la lesión se decidió realizar biopsia excisional (Figura 2). La tumoración era de un tejido elástico con límites mal definidos. No invadía los músculos recto inferior, ni recto lateral y respetaba el globo ocular (Figura 3). El material obtenido se etiquetó de sarcoma fusiforme grado 3. Dada la baja supervivencia de esta entidad, se valoró conjuntamente con el comité de oncología y se decidió plantear cirugía radical: exanteración. El paciente rechazó la misma y siguió controles posteriores. Ocho meses después el paciente seguía libre de enfermedad con estudio de PET-SCAN negativo.

Figura 1. TAC orbitaria corte coronal y sagital: En la región infero-externa del globo ocular derecho se observa una imagen ovalada de densidad similar a partes blandas con aspecto heterogéneo

Figura 2. Biopsia excisional con abordaje subciliar. Tejido elástico, límites mal definidos. No invade recto inferior ni recto lateral y respeta el globo ocular

Figura 3. Tumoración subpalpebral inferior
Histopatología
La pieza obtenida es una tumoración nodular, blanquecina y homogénea de 1,5 x 1 cm en región orbitaria derecha (Figura 4). La periferia de la lesión es lobulada y bien definida, pero hay algunas áreas de mala delimitación y contacto con el margen quirúrgico. Está formada por una proliferación fusocelular atípica de células con núcleos pleomórficos con ocasionales núcleos muy grandes e hipercromáticos (Figura 5). Las células se agrupan en fascículos que se entrecruzan en ángulo agudo. El índice mitótico es muy elevado, de 25 mitosis por 10 campos de gran aumento (X400) (Figura 6 y Figura 7). Se observan pequeños focos aislados de necrosis geográficaDesde el punto de vista inmunohistoquímico, las células expresan vimentina y, focalmente, EMA, bcl-2 y enolasa neuronal específica. La inmunotinción fue negativa para proteína S-100, citoqueratina-7, CD34 y p53. No se solicitaron marcadores musculares debido a que la morfología de la lesión no sugería en esta diferenciación. La neoplasia presenta inmunoreacción positiva con actina de músculo liso, caldesmon y calponina (focalmente) y no se tiñe con desmina, proteína S-100, queratina de amplio espectro (AE1/AE3) y p53.

Figura 4. Tinción hematoxilina-eosina. Tumoración nodular y homogénea de 1,5 x 1 cm

Figura 5. Tinción hematoxilina-eosina x 40. Proliferación fusocelular atípica de células con núcleos pleomórficos con ocasionales núcleos muy grandes e hipercromáticos
Figura 6. Tinción hematoxilina-eosina x 400. Las células se agrupan en fascículos que se entrecruzan en ángulo agudo

Figura 7. Hematoxilina-eosina x400. El índice mitótico es muy elevado, de 25 mitosis por 10 campos de gran aumento
La lesión cumplía con los 3 criterios de sarcoma radioinducido:
- Origen en el mismo lugar que una neoplasia previa
- Antecedente de radioterapia debido a la neoplasia previa
- Intervalo de unos 20 años desde el inicio de la radioterapia y la aparición de la lesión actual.
Discusión
Se presenta el caso de un joven que desarrolló un sarcoma tras haber recibido radiación externa 21 años antes para el tratamiento de un retinoblastoma intraocular, en la misma localización. El diagnóstico diferencial inicial incluía a- Sarcoma sinovial fusocelular.
- Tumor maligno de vaina nerviosa periférica.
- Sarcoma radioinducido.
Este caso sirve de ejemplo del sarcoma radioinducido de la órbita. Es una lesión muy poco frecuente pero debe ser siempre considerada en pacientes que presentan una segunda neoplasia en la misma zona del primer tumor y tienen el antecedente de radioterapia previa3,4. El estudio de anatomía patológica es fundamental, ya que para apoyar el diagnóstico de neoplasia radioinducida el tumor primario y el secundario deben ser histológicamente distintos, para descartar recidiva de la enfermedad inicial. El sarcoma radioinducido tiene muy mal pronóstico a pesar del tratamiento radical porque es quimio y radio resistente. En nuestro caso el paciente rechazó la exanteración, que hubiera sido el tratamiento radical indicado y prefirió una actitud conservadora con controles periódicos.
Bibliografía
- Abramson DH, Frank CM. Second nonocular tumors in survivors of bilateral retinoblastoma: a possible age effect on radiation-related risk. Ophthamology 1998;105:(4):573-9.
- Abramson DH, Ellsworth RM, Kitchin FD. Orbital leiomyosarcoma after retinoblastoma. Ophthalmic Surg Lasers. 1999;30:579-83.
- Pinarli FG, Oguz A, Karadeniz C, Uluoglu O, Akyurek N. Second primary myogenic sarcoma in a patient with bilateral retinoblastoma. Pediatr Hematol Oncol. 2004;21:545-50.
- Sedghizadeh PP, Angiero F, Allen CM, Kalmar JR, Rawal Y, Albright EA. Post irradiation leimyosarcoma of the maxilla: report of case in a patient with prior radiation treatment for retinoblastoma. Oral Surg Oral Med Oral Pathol Oral radiol Endod. 2004;97:726-31.

